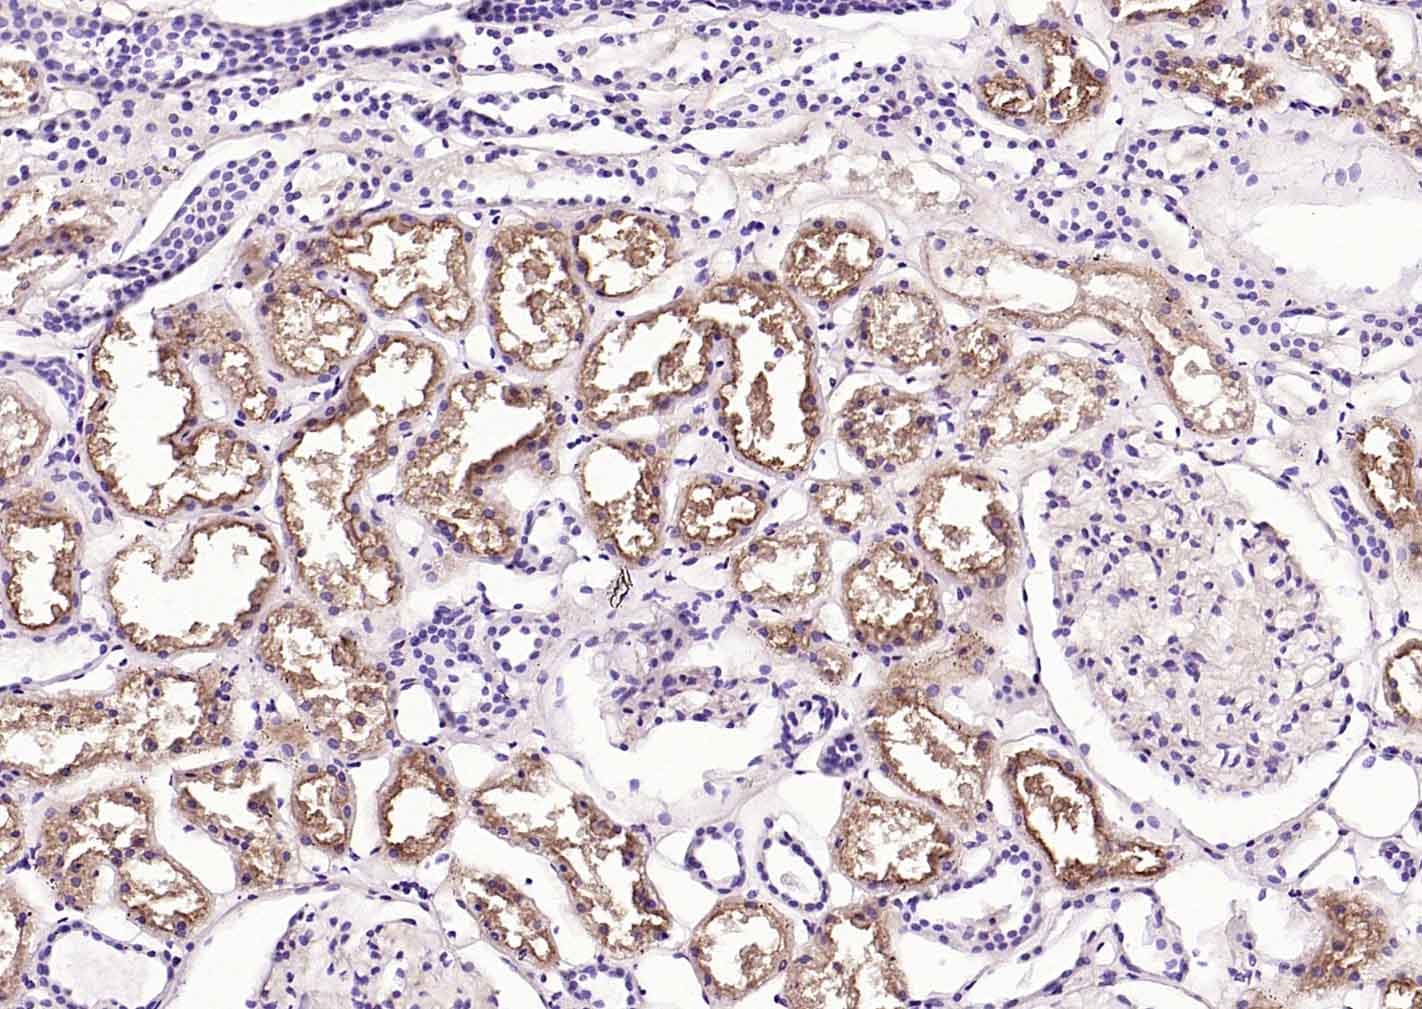
CD26D/PP4抗体

DPP4/CD26 Recombinant Rabbit mAb (一抗) - WB,IHC-P,IHC-F | Bioss
Rrmab?兔单抗

货号:bsm-60915R
产品详情
相关标记
相关产品
相关文献
常见问题
概述
产品编号
bsm-60915R
产品类型
重组兔单抗、mIHC精品抗体
英文名称
DPP4/CD26 Recombinant Rabbit mAb
中文名称
CD26D/PP4抗体
英文别名
ADABP; ADCP2; CD26; DPPIV; TP103; Dpp-4; THAM; DPP4_HUMAN; DPP4; Adenosine deaminase complexing protein 2 (ADCP-2); Dipeptidyl peptidase IV (DPP IV); T-cell activation antigen CD26; 3.4.14.5; DPP4_MOUSE; Thymocyte-activating molecule (THAM); DPP4_RAT; Bile canaliculus domain-specific membrane glycoprotein; GP110 glycoprotein;
抗体来源
Rabbit
免疫原
KLH conjugated synthetic peptide derived from human CD26
亚型
IgG
性状
Liquid
纯化方法
affinity purified by Protein A
克隆类型
Recombinant
克隆号
4C15
理论分子量
84 kDa
检测分子量
110 kDa
浓度
1mg/ml
储存液
0.01M TBS(pH7.4) with 1% BSA, 0.02% Proclin300 and 50% Glycerol.
研究领域
Cancer > Cancer Metabolism > Response to hypoxia
Cell Biology > Proteolysis / Ubiquitin > Proteolytic enzymes > Serine protease > DPPs
Immunology > Adaptive Immunity > B Cells > CD
Immunology > Adaptive Immunity > T Cells > CD
Immunology > Cell Type Markers > CD > Adhesion
Immunology > Cell Type Markers > CD > Non-lineage
Immunology > Immune System Diseases > Antiviral Signaling > HIV-related
Metabolism > Pathways and Processes > Metabolism processes > Hypoxia
Microbiology > Organism > Virus > RNA Virus > ssRNA positive strand virus > SARS Coronavirus
Stem Cells > Hematopoietic Progenitors > Lymphoid > B Lymphocytic Lineage
Stem Cells > Hematopoietic Progenitors > Lymphoid > T Lymphocytic Lineage
SWISS
Gene ID
保存条件
Shipped at 4℃. Store at -20 °C for one year. Avoid repeated freeze/thaw cycles.
注意事项
This product as supplied is intended for research use only, not for use in human, therapeutic or diagnostic applications.
数据库链接
产品介绍
CD26是细胞表面上一种氨基肽酶,具有丝氨酸蛋白酶活性,属于丝氨酸蛋白酶s9b家族,分布于多种细胞表面或游离于胞浆中,具有高度保守的蛋白水解酶活性. 还是一种细胞膜受体、共刺激分子,参与机体免疫调节、细胞迁移、细胞黏附和细胞凋亡.
背景资料
The DPP4 gene encodes dipeptidyl peptidase 4, which is identical to adenosine deaminase complexing protein-2, and to the T-cell activation antigen CD26. It is an intrinsic type II transmembrane glycoprotein and a serine exopeptidase that cleaves X-proline dipeptides from the N-terminus of polypeptides. Dipeptidyl peptidase 4 is highly involved in glucose and insulin metabolism, as well as in immune regulation. This protein was shown to be a functional receptor for Middle East respiratory syndrome coronavirus (MERS-CoV), and protein modeling suggests that it may play a similar role with SARS-CoV-2, the virus responsible for COVID-19. [provided by RefSeq, Apr 2020]

产品应用
| 应用 | 已检合格种属 | 预测种属 | 推荐稀释比例 |
|---|---|---|---|
| WB | Human, Rat | Mouse | 1:500-2000 |
| IHC-P | Human, Mouse, Rat | 1:100-500 | |
| IHC-F | Human, Mouse, Rat | 1:100-500 |
交叉反应
交叉反应: Human, Mouse, Rat
相关产品
暂无相关产品
靶标
基因名
DPP4
蛋白名
Dipeptidyl peptidase 4
亚细胞定位
Cell membrane. Apical cell membrane. Cell projection > invadopodium membrane. Cell projection > lamellipodium membrane. Cell junction. Membrane raft. Translocated to the apical membrane through the concerted action of N- and O-Glycans and its association with lipid microdomains containing cholesterol and sphingolipids. Redistributed to membrane rafts in T-cell in a interleukin-12-dependent activation. Its interaction with CAV1 is necessary for its translocation to membrane rafts. Colocalized with PTPRC in membrane rafts. Colocalized with FAP in invadopodia and lamellipodia of migratory activated endothelial cells in collagenous matrix. Colocalized with FAP on endothelial cells of capillary-like microvessels but not large vessels within invasive breast ductal carcinoma. Colocalized with ADA at the cell junction in lymphocyte-epithelial cell adhesion. Colocalized with IGF2R in internalized cytoplasmic vesicles adjacent to the cell surface and Secreted. Detected in the serum and the seminal fluid.
组织特异性
Expressed specifically in lymphatic vessels but not in blood vessels in the skin, small intestine, esophagus, ovary, breast and prostate glands. Not detected in lymphatic vessels in the lung, kidney, uterus, liver and stomach (at protein level). Expressed in the poorly differentiated crypt cells of the small intestine as well as in the mature villous cells. Expressed at very low levels in the colon.
翻译后修饰
The soluble form (Dipeptidyl peptidase 4 soluble form also named SDPP) derives from the membrane form (Dipeptidyl peptidase 4 membrane form also named MDPP) by proteolytic processing.
N- and O-Glycosylated.
Phosphorylated. Mannose 6-phosphate residues in the carbohydrate moiety are necessary for interaction with IGF2R in activated T-cells. Mannose 6-phosphorylation is induced during T-cell activation.
N- and O-Glycosylated.
Phosphorylated. Mannose 6-phosphate residues in the carbohydrate moiety are necessary for interaction with IGF2R in activated T-cells. Mannose 6-phosphorylation is induced during T-cell activation.
相似性
Belongs to the peptidase S9B family. DPPIV subfamily.
功能
Cell surface glycoprotein receptor involved in the costimulatory signal essential for T-cell receptor (TCR)-mediated T-cell activation. Acts as a positive regulator of T-cell coactivation, by binding at least ADA, CAV1, IGF2R, and PTPRC. Its binding to CAV1 and CARD11 induces T-cell proliferation and NF-kappa-B activation in a T-cell receptor/CD3-dependent manner. Its interaction with ADA also regulates lymphocyte-epithelial cell adhesion. In association with FAP is involved in the pericellular proteolysis of the extracellular matrix (ECM), the migration and invasion of endothelial cells into the ECM. May be involved in the promotion of lymphatic endothelial cells adhesion, migration and tube formation. When overexpressed, enhanced cell proliferation, a process inhibited by GPC3. Acts also as a serine exopeptidase with a dipeptidyl peptidase activity that regulates various physiological processes by cleaving peptides in the circulation, including many chemokines, mitogenic growth factors, neuropeptides and peptide hormones. Removes N-terminal dipeptides sequentially from polypeptides having unsubstituted N-termini provided that the penultimate residue is proline.
同靶标产品
相关文献
提示: 发表研究结果有使用 bsm-60915R 时请让我们知道,以便我们可以引用参考文章。作为回馈,资料提供者将获得我们送上的小礼品。
具体参考文献:bsm-60915R 被引用于1文献中